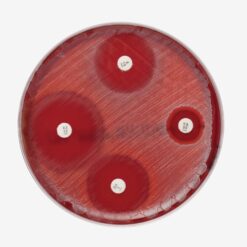
Müller-Hinton-Blutagar
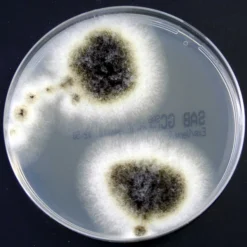
Sabouraud Glucose Selektivagar mit Chloramphenicol und Gentamicin

Nährböden
Ab 6,30 €
| Variante | Columbia-Agar mit Schafblut, 10 Stück, Staphylokokken/Streptokokken-Selektivagar, 10 Stück, MacConkey-Agar, 10 Stück, Müller-Hinton-Agar, 10 Stück, CLED Agar, 10 Stück, Candida-Selektivagar nach Nickerson, 10 Stück, DST-Agar, 10 Stück, CLED-/MacConkey-Agar Doppelplatte, 10 Stück |
|---|
Ähnliche Produkte
7,85 €
77,96 €
15,97 €
1,20 €
Nährböden
0,98 €
36,10 €
6,98 €
Nährböden
7,98 €
11,15 €
12,70 €
15,95 €